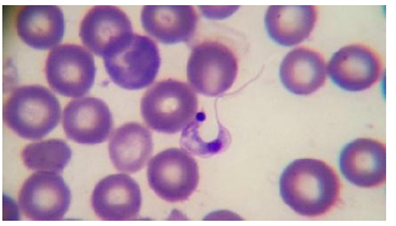

Introducción
La enfermedad de Chagas o tripanosomiasis americana es un padecimiento infeccioso causado por el parásito flagelado Trypanosoma cruzi. Esta enfermedad afecta de 6-8 millones de personas en el mundo y causa aproximadamente 50 mil muertes por año (Lidani et al., 2019). En Latinoamérica es uno de los principales problemas de salud, y, en el Sureste mexicano están identificadas 18 áreas endémicas (Carabarin-Lima et al., 2013), sin embargo, el padecimiento va en ascenso en lugares originalmente no-endémicos, como Europa, los Estados Unidos de América, Canadá, Australia y Japón (Lidani et al., 2019), países en los que la transmisión es por transfusión sanguínea, trasplante de órganos, transmisión congénita o vertical (de madre a hijo) o por accidentes de laboratorio. También se han reportado casos de transmisión por vía oral, por ingestión de alimentos o bebidas contaminadas con heces del vector (Carabarin-Lima et al., 2013; Bern, 2015).
En las zonas endémicas de la enfermedad, T. cruzi se transmite al humano, u otro mamífero, al contacto con las heces del vector, luego de que el insecto triatomino (Hemiptera: Reduviidae) se alimentó de su sangre. El parásito presenta tres estadios morfológicos durante su ciclo de vida: amastigote, epimastigote y tripomastigote, que se identifican por la posición del cinetoplasto en relación con el núcleo (Figura 1) (Martins et al., 2012; Moreno et al., 2019).

Elaboración personal.
Figura 1 Localización y morfología de T. cruzi en sus estadios. a) amastigotes en los tejidos del huésped vertebrado. El cinetoplasto es pequeño y se ubica en posición anterior al núcleo. b) epimastigotes en el intestino medio del vector y en cultivo axénico. El cinetoplasto se ubica en posición anterior al núcleo. c) tripomastigotes metacíclicos en los tubos de Malpighi (recto) y las heces del vector. tripomastigotes sanguíneos en el torrente del hospedero vertebrado. El cinetoplasto se ubica en posición posterior al núcleo. n: núcleo, c: cinetoplasto.
T. cruzi tiene una amplia diversidad genética en distintas zonas geográficas, producto de sus mecanismos de reproducción. Las cepas o aislados del parásito se han agrupado en siete unidades de tipificación discretas o DTU, nombradas TcI a TcVI y Tcbat; las diferencias en el comportamiento y la virulencia entre las DTUs se atribuyen a la interacción entre el ambiente, el hospedero y el vector. Estos aislados pueden caracterizarse en modelos animales, principalmente ratones, midiendo parámetros de virulencia como el periodo prepatente, la mortalidad/supervivencia, la parasitemia y el tropismo hacia órganos blanco (De Fuentes-Vicente et al., 2019).
La presencia de T. cruzi tiene efectos en el insecto transmisor durante su paso por los segmentos del tracto digestivo de éste, donde enfrenta la acción de diferentes enzimas. Aunque tradicionalmente se afirma que el parásito no tiene efecto alguno sobre el vector, estudios recientes demuestran que es capaz de modificar el comportamiento del insecto al activar su sistema inmune y alterar la microbiota asociada (Kollien & Schaub, 2000; Schaub, Meiser & Balczun, 2011; Jiménez-Cortés et al., 2020).
La evolución clínica de la enfermedad de Chagas en el hospedero humano suele dividirse en una etapa aguda de la enfermedad y otra crónica; esta última puede presentarse de forma indeterminada, donde no existe síntoma alguno, o bien causar problemas como cardiomegalia o digestivos. En todas las fases, la respuesta inmune es crucial para controlar la enfermedad (Salazar-Schettino et al., 2016).
La enfermedad de Chagas se detecta en los pacientes al realizarles estudios epidemiológicos o tamizajes para la donación de sangre. El diagnóstico durante la etapa aguda depende principalmente de la localización microscópica del parásito en la sangre. En la fase crónica, el diagnóstico se basa en pruebas serológicas y estudios de gabinete.
En el tratamiento de la enfermedad de Chagas se utilizan dos fármacos: Nifurtimox y benznidazol, eficaces para la fase aguda y los casos congénitos. La distribución de ambos medicamentos es controlada, y solo se obtienen en la Secretaría de Salud en México (Lidani et al., 2019). Por lo hasta aquí expuesto, es necesario disminuir la transmisión de la enfermedad, ampliar el diagnóstico oportuno y la fabricación de nuevos medicamentos que sean efectivos para la fase crónica sin ser tóxicos para el paciente. El objetivo de esta revisión es abordar aspectos selectos de la biología de Trypanosoma cruzi para comprender mejor la dinámica de su transmisión.
Descubrimiento de la enfermedad de chagas y T. cruzi
La enfermedad de Chagas lleva el nombre de su descubridor, el bacteriólogo brasileño Carlos Ribeiro Justiniano Chagas (1879-1934), quien en 1908 organizó una campaña contra la malaria en el estado de Minas Gerais, Brasil. Chagas comenzó el estudio con la disección de varios insectos hematófagos que solían picar a la gente en la cara y encontró numerosos parásitos en su intestino medio, a los que dio el nombre taxonómico para el género y la especie de Trypanosoma cruzi en honor a su tutor, el médico y bacteriólogo Oswaldo Cruz (Steverding, 2014). Con estos insectos logró infectar animales de laboratorio, y detectó a los tripanosomas en su sangre días después de que éstos fueron picados por las chinches. Al descubrir el agente etiológico, demostró que en mamíferos se lleva a cabo una fase de su ciclo de vida. En 1909, examinó a una niña de 2 años llamada Berenice, quien presentaba síntomas específicos de lo que hoy se conoce como la fase aguda de la enfermedad (fiebre, inflamación en órganos como el bazo y el hígado, edema facial [hinchazón] y ganglios linfáticos inflamados). Al examinar su sangre, encontró una gran cantidad de microorganismos con una morfología similar a la de los parásitos con los que se habían infectado los animales de laboratorio que estudió previamente (monos tití); con ello, pudo describir la fase aguda de la enfermedad y finalmente asociar la infección con síntomas crónicos (Steverding, 2014; Lidani et al., 2019). Berenice, su primera paciente, permaneció asintomática y nunca desarrolló la fase crónica de la enfermedad; no obstante, se confirmó que estuvo infectada con T. cruzi a lo largo de su vida cuando se le extrajo sangre para aislar al parásito como parte de los estudios clínicos en los que se le incluyó, a los 55 y 71 años y quien finalmente, murió a los 73 años por causas ajenas a la enfermedad (Steverding, 2014; Lidani et al., 2019). En 1912, el Dr. Chagas describió el ciclo silvestre de la enfermedad cuando descubrió que el armadillo era un reservorio natural de T. cruzi, y en el mismo ecotopo encontró que el triatomino Panstrongylus geniculatus se encontraba infectado con el parásito (Coura & Dias, 2009). Posteriormente, se descubrieron más animales, de vida silvestre, como reservorios naturales del parásito con un ciclo enzoótico (enfermedad que involucra a una o más especies de animales en determinado territorio, por causa o influencia local) de T. cruzi. Otros investigadores también hicieron grandes aportes al descubrimiento de la enfermedad; por ejemplo, el patólogo brasileño Gaspar de Oliveira Vianna describió la forma de amastigote de T. cruzi, el parasitólogo francés Alexandre Joseph Émile Brumpt determinó los mecanismos de transmisión de T. cruzi (Steverding, 2014). Posterior a la muerte de Carlos Chagas, Evandro Chagas (su hijo) y Emmanuel Dias (alumno y asistente) establecieron el carácter endémico y crónico de la enfermedad (Lidani et al., 2019). Evandro Chagas, Emmanuel Dias y Magarinos Torres propusieron el nombre de “signo de Romaña” para el complejo oftálmico que caracteriza a la fase aguda de la infección. En 1943, se creó el centro de investigación de Bambuí en Brasil, para difundir el conocimiento sobre la epidemiología, la prevención y la cardiopatía que acompaña a la enfermedad de Chagas (Coura & Dias, 2009; Steverding, 2014). Zigman Brener demostró que la enfermedad de Chagas producida de forma experimental podía curarse, y esto dio pie a mayores investigaciones para tratar la fase aguda de la enfermedad, así como para el estudio de un posible tratamiento. En 1966, Hoffmann-La Roche comercializó el benznidazol para tratar la enfermedad de Chagas, y Bayer fabricó el Nifurtimox en 1970. Entre 1970 y 1980, Zigman Brener reportó avances en la inmunología y la inmunopatología de la enfermedad, y aportó nuevos conocimientos sobre la biología del parásito, la respuesta del hospedero y medidas diversas de profilaxis (Coura & Dias, 2009; Steverding, 2014). En 1983, se estableció el control vectorial para la enfermedad de Chagas en Brasil; estas iniciativas se extendieron a otros países endémicos, y recientemente se establecieron en países no-endémicos como respuesta a la migración (Coura & Dias, 2009; Lidani et al., 2019).
Morfología de T. cruzi
Trypanosoma cruzi es un parásito intracelular hemoflagelado del orden Kinetoplastid a, familia Trypanosomatidae; esta familia se caracteriza por la presencia de un flagelo y una única y ramificada mitocondria, que se extiende por todo el cuerpo celular (Lidani et al., 2019; Moreno et al., 2019). La membrana plasmática de T. cruzi está compuesta por una bicapa lipídica que incluye proteínas y un glucocálix; con la presencia de ácido siálico asociado con glucopéptidos (un elemento importante en la interacción del parásito con los macrófagos del hospedero) (Martins et al., 2012).
Se han descrito diferentes organelos en el citoplasma del parásito. La mitocondria tiene una apariencia ramificada y presenta una doble membrana directamente relacionada con el cinetoplasto, una estructura circular característica de los organismos del orden Kinetoplastida que contiene el DNA mitocondrial del parásito, conocido también como k-DNA. El cinetoplasto solo es circular en el estadio de tripomastigote, en amastigote y epimastigote es de forma alargada (Pech-Canul et al., 2017). El DNA mitocondrial asociado con el inicio del flagelo y cercano al núcleo, se organiza en estructuras atípicas llamadas maxicírculos y minicírculos, que representan cerca del 30% del genoma celular. Los genes codificadores de las proteínas mitocondriales que se localizan en los maxicírculos muestran errores de marco de lectura que obligan a procesar los transcritos por adición y deleciones de uridinas (edición de RNA). Estas ediciones requieren, para el procesamiento adecuado del RNA, guías que se encuentran codificadas en los minicírculos. Maxicírculos y minicírculos están concatenados, lo que da al DNA una densidad peculiar que determina su prominencia estructural en tinciones especiales (De Souza, Carvalho & Barrias, 2017).
El flagelo está compuesto por nueve pares de microtúbulos (distribuidos en forma de círculo) y dos microtúbulos centrales dentro de una matriz citoplasmática rodeada por una membrana. Adicionalmente, contiene una estructura llamada bastón paraflagelar (paraflagellar rod, PRF), compuesto de un arreglo de filamentos ligados al axonema (De Souza et al., 2017).
El cinetosoma o cuerpo basal es una continuación del flagelo y está vinculado con el cinetoplasto por medio de filamentos proteicos. El citostoma es una invaginación de la membrana plasmática, implicada en la actividad endocítica del parásito, especialmente en los epimastigotes, donde es responsable del 85% de la endocitosis. En la base del flagelo se encuentra el bolsillo flagelar, una invaginación por la que el flagelo emerge. El flagelo se mantiene en su sitio gracias al complejo tripartita de adhesión (tripartite attachment complex, TAC), que fija el DNA mitocondrial a la base del flagelo. El parásito también contiene glicosomas, estructuras esféricas o alargadas, consideradas un tipo de peroxisomas por la presencia de enzimas glucolíticas. El aparato de Golgi interviene en la glicosilación proteica, mientras que los reservosomas contienen proteasas y almacenan proteínas provenientes de la actividad endocítica (éstos desaparecen durante la transformación de epimastigotes a tripomastigotes). Las vesículas endocíticas brotan del citostoma (primordialmente) y del bolsillo flagelar. Estas vesículas se fusionan con los reservosomas, que contienen cruzipaína (una cisteína proteasa). La enzima se expresa en los tres estadios del parásito (se describen a continuación), y está presente en organelos relacionados con los lisosomas; la mayor concentración de cruzipaína se encuentra en los reservosomas. Las isoformas menos abundantes se expresan en la membrana del parásito, y es más importante en los amastigotes. Los tripomastigotes secretan algunas isoformas hacia el medio, y se cree que son importantes como factores de virulencia. El acidocalcisoma es un organelo encargado del almacenamiento del calcio, magnesio, sodio, potasio, fósforo y zinc; de regular la homeostasis, y de la osmorregulación del pH (Martins et al., 2012; De Souza et al., 2017). Como mencionamos antes, los tres estadios en el ciclo de vida del parásito, amastigote, epimastigote y tripomastigote, se identifican por la posición en que se encuentra el cinetoplasto en relación con el núcleo (Figura 1). El amastigote, es la forma intracelular del parásito que se localiza en los tejidos del huésped vertebrado, se multiplica por fisión binaria longitudinal. Está desprovisto del flagelo exterior y de la membrana ondulante; es redondeado y mide de 2 a 6.5 μm de diámetro. Su cinetoplasto se localiza cerca del núcleo, en una posición anterior. El epimastigote se encuentra en el intestino medio del vector (triatomino), y también se obtiene de cultivos axénicos. Su morfología celular es alargada, con un flagelo libre, una membrana ondulante poco desarrollada y mide entre 20 y 40 μm, incluido el flagelo; su cinetoplasto está en posición anterior al núcleo, y también se replica por fisión binaria longitudinal. Los tripomastigotes no se replican, son de localización extracelular, poseen una membrana ondulante y se aíslan a partir de los hospederos invertebrados (vectores) y vertebrados (animales reservorios y humanos); en consecuencia, el tripomastigote metacíclico se localiza en el recto del vector y en sus heces. El tripomastigote metacíclico tiene una forma alargada y un flagelo; mide alrededor de 17 μm; su núcleo es grande, y el cinetoplasto está en posición posterior terminal. El tripomastigote sanguíneo está presente en la sangre y otros fluidos corporales (líquido cefalorraquídeo, linfa) de los huéspedes vertebrados. Este tripomastigote posee un flagelo largo (un tercio de la longitud total del parásito) y llega a medir hasta 20 μm, incluyendo el flagelo. Al igual que en el tripomastigote metacíclico, el cinetoplasto se ubica después del núcleo; es decir, en una posición posterior (Martins et al., 2012; Moreno et al., 2019).
Ciclo de vida de T. cruzi
El ciclo de vida del parásito comienza cuando un triatomino infectado (adulto o ninfa, macho o hembra) pica al hospedero (vertebrado). Después de ingerir una gran cantidad de sangre, el vector defeca sobre la superficie de la piel del humano u otra especie de mamífero; las heces depositadas en la piel del hospedero contienen tripomastigotes metacíclicos. Por lo regular, la picadura causa escozor, por lo que el hospedero frota la zona afectada, y de este modo el parásito puede penetrar la piel o las mucosas (Martins et al., 2012; Álvarez-Hernández et al., 2018). Una vez que los tripomastigotes metacíclicos atraviesan la piel, circulan como tripomastigotes sanguíneos, pero también puede ocurrir una fagocitosis inducida, en la que los parásitos son endocitados por diversas células, incluidos los macrófagos (Martins et al., 2012; Salazar-Schettino et al., 2016). Dentro de la célula huésped se forma una vacuola parasitófora; los tripomastigotes escapan de esa vacuola y se liberan al citoplasma, donde posteriormente se transforman en amastigotes y se multiplican. Esto ocurre dentro de todas las células del huésped, excepto en los eritrocitos, porque carecen de purinas y éstas son necesarias para los requerimientos de T. cruzi (Schaub et al., 2011). Los amastigotes provocan la ruptura de las células infectadas, y pasan al estadio de tripomastigotes sanguíneos (Rassi, Rassi & Marin-Neto, 2010; Schaub et al., 2011; Martins et al., 2012). Los tripomastigotes sanguíneos lisan las células que los contienen y se liberan a la circulación; viajan por los vasos linfáticos y el torrente sanguíneo para invadir otras células (musculares y ganglionares, principalmente), donde se multiplican intracelularmente y están disponibles para infectar vectores que se alimentan del huésped infectado (Rassi et al., 2010; Bern, 2015). El triatomino al alimentarse de la sangre de un hospedero infestado ingiere los tripomastigotes sanguíneos, que llegan a su estómago y posteriormente al intestino medio, donde se transforman en epimastigotes. Éstos, a continuación, migran hacia el recto o intestino posterior del vector, y ahí ocurre la diferenciación a tripomastigotes metacíclicos infecciosos, que finalmente se liberan en las heces del triatomino mientras éste se alimenta de otro hospedero vertebrado. El proceso de diferenciación que ocurre a lo largo del intestino del vector se llama metaciclogénesis (Martins et al., 2012; Onyekwelu, 2019) (Figura 2).

Elaboración personal.
Figura 2 Ciclo de vida de Trypanosoma cruzi. a) El triatomino se alimenta del huésped y deyecta; las heces que contienen tripomastigotes metacíclicos, que penetran la piel e infectan a las células. b) Dentro de las células, los tripomastigotes metacíclicos se transforman en amastigotes. c) Los amastigotes se multiplican por fisión binaria en los tejidos y se transforman en tripomastigotes sanguíneos. d) Los tripomastigotes sanguíneos lisan las células que los contienen y entran en el torrente sanguíneo. e) Los tripomastigotes sanguíneos pueden infectar otras células y transformarse en amastigotes. f) El triatomino se alimenta con la sangre del huésped infectado e ingiere tripomastigotes sanguíneos. g) Los tripomastigotes sanguíneos se transforman en epimastigotes en el intestino medio del vector. h) Los epimastigotes se multiplican en el intestino medio y migran hacia el recto del vector. i) En el recto, los epimastigotes se transforman en tripomastigotes metacíclicos y se liberan con las heces del triatomino. Se han identificado distintos animales reservorios, (perros, gatos, roedores y armadillos), del parásito.
Virulencia en aislados de T. cruzi
Las diferencias en el comportamiento biológico de distintos aislados reportadas en estudios in vitro e in vivo explican las variaciones clínicas de la enfermedad (Suárez, Cabrera, Cartagena & Ayaqui, 2009; Guzmán-Marín, Jiménez-Coello, Puerto-Solís, Ortega-Pacheco & Acosta-Viana, 2012). Esta diversidad se atribuye a múltiples causas, incluso a factores ambientales, inmunidad del huésped, virulencia, patogenicidad y la interacción con vectores y hospederos diferentes (Guzmán-Marín et al., 2012; De Fuentes-Vicente et al., 2019).
La patogenicidad se define como “la capacidad de un microorganismo para causar daño en un huésped” (Soriano, Salgado-Miranda, Suárez -Guemes & Trigo-Tavera, 2006). Un eje de la variación de la patogenicidad entre los aislados de T. cruzi se relaciona a su gran heterogeneidad genética; sin embargo, otros ejes se vinculan con el insecto vector (que puede modular la virulencia y el comportamiento del parásito) y con factores inmunológicos, genéticos y nutricionales del huésped humano, que influyen en la respuesta a la infección (Barrera-Pérez, Rodríguez-Félix, Guzmán-Marín, Zavala-Velázquez & Dumonteil, 2001). Esto implica que es necesario caracterizar las cepas de diferentes áreas geográficas para entender el comportamiento epidemiológico y clínico de la enfermedad (Barrera-Pérez et al., 2001).
Por otro lado, la virulencia se define como “el grado en que causa daño un microorganismo en un huésped” (Soriano et al., 2006). La virulencia de cada aislado de T. cruzi se mide en parámetros como el periodo prepatente (tiempo transcurrido desde la infección hasta la detección de tripomastigotes en la sangre periférica del huésped, que indica la tasa de replicación del parásito), la parasitemia (número de parásitos por mililitro de sangre del huésped vertebrado), el tropismo celular (diferentes cepas de T. cruzi muestran preferencia por tejidos específicos) y la mortalidad (porcentaje de animales de experimentación que murieron en el curso de la infección) (Guzmán-Marín, Zavala-Castro, Acosta-Viana & Rosado-Barrera, 1999; Suárez et al., 2009; De Fuentes-Vicente et al., 2019).
La identificación biológica y bioquímica de diferentes aislados de T. cruzi nos ayuda a entender las variaciones que se presentan en la relación parásito-hospedero y a distinguir componentes relevantes involucrados en la misma útiles para el serodiagnóstico de la enfermedad (Mendoza-Rodríguez, 2015). La caracterización de los aislados es también una condición necesaria para su estudio y control (Guzmán-Marín et al., 1999).
En la Tabla I se mencionan varios estudios de cepas de T. cruzi aisladas de distintos hospederos de varias localidades de la República mexicana; en ella se muestran variaciones en la parasitemia, la supervivencia y el tropismo. Por ejemplo, se observa que los aislados obtenidos del vector Triatoma barberi pueden ser más virulentos que los parásitos recuperados de Meccus pallidipennis, al considerar que en los primeros se observó una parasitemia de 21 × 106 parásitos/mL y en el hospedero la mortalidad fue a los 8 días, mientras que en los segundos se produjeron menores niveles de parasitemia, 1.08 × 106 parásitos/mL, y la mortalidad ocurrió a los 59 días. Los estudios con datos sobre el tropismo muestran una mayor afección cardiaca.
Tabla I Aislados de T. cruzi obtenidos en localidades de México.
| Autor (es) y año | Hospedero | Localidad | Periodo prepatente (días)* | Mortalidad (días)** | Parasitemia promedio (parásitos/mL)*** | Tropismo (%)**** |
|---|---|---|---|---|---|---|
| Tay, Gutiérrez-Quiroz, Salazar-Schettino, Castillo & Ortega-G., 1973 | Homo sapiens | Jojutla, Morelos | SD | SD | 16 × 106 |
|
| Triatoma phyllosoma mazzottii | Tetitlán, Guerrero | SD | SD | 3.5 × 106 |
|
|
| Triatoma phyllosoma pallidipennis | Las Higueras, Morelos | SD | SD | 1.5 × 106 |
|
|
| Triatoma barberi | La Mesa, Michoacán | SD | SD | 7×106 |
|
|
| Triatoma barberi | El Capulín, Michoacán | SD | SD | 6.5 × 106 |
|
|
| Triatoma phyllosoma intermedia | Estanzuela, Zacatecas | SD | SD | 7×106 |
|
|
| Salazar-Schettino, Tay, Navarrete & Ramos, 1975 | Triatoma phyllosoma mazzottii | Cocula, Jalisco | SD | SD | 9.8 × 107 |
|
| Salazar-Schettino, Jiménez, Tay & Cárdenas-Ramírez, 1978 | Homo sapiens | Jalisco | 6 | 21 | 2.5 × 107 |
|
| Triatoma barberi | Santa Catarina, Jalisco | 6 | 21-30 | 1.6 × 107 |
|
|
| Triatoma barberi | Zacoalco, Jalisco | 3 | 30 | 1.5 × 107 |
|
|
| Triatoma barberi | La Cruz, Jalisco | 9 | 30 | 1×107 |
|
|
| Triatoma barberi | Miahuatlán, Oaxaca | SD | 25 | 24 × 106 |
|
|
| Salazar-Schettino, Haro, Tay, Bucio & Robert, 1987 | Triatoma barberi | Santo Domingo, Oaxaca | SD | 15-28 | 8×106 |
|
| Homo sapiens | Yucatán | SD | 30 | 2×106 |
|
|
| Homo sapiens | Jalisco | SD | 18 | 40 × 106 |
|
|
| Aguilar-Díaz, 2004 | Triatoma barberi | La Cueva, Querétaro | 2 | 8 | 21 × 106 |
|
| Triatoma pallidipennis | Tequesquitengo, Morelos | 6 | 30 | 44 × 106 |
|
|
| Triatoma dimidiata | Xalapa, Veracruz | 2 | 18 | 12 × 106 |
|
|
| Monteón et al., 2009 | Homo sapiens | Oaxaca | 10 | 28 | 2.5 × 105 |
|
| Homo sapiens | Veracruz | 10 | 30 | 5.0 × 105 |
|
|
| Homo sapiens | Guerrero | 10 | 29 | 2.6 × 105 |
|
|
| Triatoma dimidiata | Campeche | 10 | 30 | 6×105 |
|
|
| Triatoma picturata | Tepic, Nayarit | 10 | 29 | 1.5 × 105 |
|
|
| Espinoza et al., 2010,2011 | Homo sapiens | Oaxaca | 7 | 90 | 1.6 × 106 |
|
| Triatoma barberi | Querétaro | 3 | 50 | 2.9 × 106 | ||
| Gómez-Hernández et al., 2011 | Triatoma longipennis | Jalisco | 2-11 | SD | SD |
|
| Triatoma pallidipennis | Jalisco | 2-11 | 41 | SD |
|
|
| Triatoma longipennis | Jalisco | 2-11 | 40 | 1×107 |
|
|
| Triatoma pallidipennis | Jalisco | 2-11 | 45 | 4.6 × 106 |
|
|
| Triatoma pallidipennis | Jalisco | 2-11 | 46 | 8×106 |
|
|
| Triatoma picturata | Jalisco | 2-11 | SD | SD |
|
|
| Homo sapiens | Oaxaca | 2-11 | 41 | 7.5 × 106 |
|
|
| Homo sapiens | Guanajuato | 2-11 | 48 | 6.1 × 106 |
|
|
| Guzmán-Marín et al., 2012 | Homo sapiens | Yucatán | 8 | 32 | 115 × 105 |
|
| Didelphis marsupialis | Yucatán | 8 | 45 | 295 × 105 |
|
|
| Triatoma dimidiata | Yucatán | 12 | 45 | 190 × 105 |
|
|
| Meccus pallidipennis | Morelos | 18 | 59 | 1.08 × 106 |
|
|
| Mendoza-Rodríguez, 2015 | Meccus pallidipennis | Morelos | 17 | 100 | 3.9 × 106 |
|
| Triatoma barberi | Querétaro | 3 | 17 | 2.9 × 107 |
|
|
| Triatoma barberi | Querétaro | 3 | 29 | 4.2 × 107 |
|
|
| Medina-Buelvas, Rodríguez-Sosa & Vega, 2021 | Homo sapiens | Oaxaca | 8 | SD | 3.5 × 106 |
|
SD: Sin dato. *Periodo prepatente: día en que se observan por primera vez los parásitos en la sangre posterior a la inoculación. **Mortalidad: día en el que se presentaron el 100% de muertes. ***Parasitemia promedio: parásitos por mililitro. ****Tropismo: Nidos de amastigotes presentes en los tejidos, se considera el 100% como la cifra más alta.
Diversidad genética de T. cruzi
El principal mecanismo de reproducción en T. cruzi es asexual, por fisión binaria, aunque hay evidencia de hibridación, intercambio genético entre aislados y reproducción sexual. Existen dos teorías sobre la diversidad genética del parásito: (1) la teoría clonal, donde se propone que todos los descendientes poseen un genotipo igual al fundador y no existe recombinación, y (2) la posibilidad de que T. cruzi se reproduzca sexualmente por un mecanismo similar a la meiosis (Zingales et al., 2012; Herreros-Cabello, Callejas-Hernández, Girones & Fresno, 2020).
Se han reportado variaciones en el tamaño y el número de cromosomas entre los aislados del parásito, e incluso entre clonas. T. cruzi se ha descrito usualmente como diploide, con cromosomas que varían de 0.45 a 4 Mb en tamaño, y de 19 a 40 en número. El tamaño total del genoma se estima entre 80 y 150 Mb (Herreros-Cabello et al., 2020).
El universo de cepas conocidas hasta ahora se divide en siete unidades de tipificación discretas (DTU), llamadas TcI a TcVI y Tcbat (Tabla II). Un comité de expertos reconoció esta división en 2009, y propuso aplicar este consenso para la nomenclatura intraespecífica de T. cruzi (Zingales, 2018). Las DTU son “conjuntos de poblaciones que están genéticamente más relacionadas entre sí que con cualquier otra población y que son identificables por un marcador genético, molecular o inmunológico común” (Zingales et al., 2009; 2012). Las DTU son unidades de análisis confiables para la epidemiología molecular y los estudios experimentales de la evolución del parásito. Su comprensión aporta conocimientos para orientar la investigación y las intervenciones futuras contra la enfermedad (Zingales et al., 2012).
Tabla II Unidades de Tipificación Discretas (DTUs) en Trypanosoma cruzi.
| DTU | Manifestaciones clínicas | Localización |
|---|---|---|
| TcI | Miocardiopatía chagásica y meningoencefalitis asociada a los pacientes con SIDA | Amazonia, América del Norte (México y Estados Unidos), Centro y Sur (Colombia y Venezuela) |
| TcII | Cardiomiopatía y megasíndromes digestivos | Brasil y Cono Sur |
| TcIII | Rara en humanos | De Venezuela hasta Argentina |
| TcIV | Brotes orales | América del Norte y del Sur |
| TcV | Cardiomiopatía y megasíndromes digestivos | Cono Sur, Gran Chaco |
| TcVI | Cardiomiopatía y megasíndromes digestivos | Ecuador, Colombia, Cono Sur y el Gran Chaco |
| Tc bat | Presente en murciélagos | Panamá, Colombia y Brasil |
T. cruzi TcI está distribuida principalmente en la Amazonia, la región andina, América del Norte (México y Estados Unidos), países de Centroamérica y el norte de Sudamérica (Colombia y Venezuela) (Zingales et al., 2012; Zingales, 2018), y se transmite por medio de vectores de los géneros Rhodnius, Panstrongylus y Triatoma (Messenger, Miles & Bern, 2015). Esta DTU se asocia con ciclos domésticos y silvestres; sus principales características clínicas son la miocardiopatía chagásica y la meningoencefalitis en pacientes inmunocomprometidos (Zingales et al., 2012). En México se ha localizado principalmente la variante TcI. No se ha reportado la caracterización molecular de los aislados que se muestran en la Tabla II; sin embargo, la patología en modelos murinos indica que son cepas cardiotrópicas, que coinciden con la sintomatología presente con mayor frecuencia en el país, en comparación con los daños al sistema digestivo que ocurren en otras DTU (Zingales, 2018).
T. cruzi TcII predomina en el este y el centro de Brasil (Zingales et al., 2012) y en el Cono Sur (Messenger et al., 2015); asociado principalmente con ciclos de transmisión doméstica, está presente en los vectores Triatoma infestans y Panstrongylus megistus. Suele ocasionar cardiomiopatía y megasíndromes digestivos (megaesófago y megacolon) (Messenger et al., 2015).
La variante TcIII se encuentra desde el noreste de Venezuela hasta Argentina, donde es transmitida por Panstrongylus geniculatus, P. lignarius y Triatoma rubrovaria (Messenger et al., 2015). Se asocia con ciclos silvestres en Brasil y países adyacentes, principalmente en nichos de Dasypus novemcinctus. Esta DTU es rara en humanos, y está prácticamente ausente en las infecciones crónicas; sin embargo, se ha reportado en casos agudos en la Amazonia brasileña (Zingales et al., 2012; Cura & Schijman, 2013).
T. cruzi TcIV se localiza en América del Norte y del Sur; es el agente secundario de la enfermedad de Chagas en Venezuela, y se han reportado casos de brotes orales en la Amazonia brasileña (Zingales, 2018). Está presente en vectores de los géneros Rhodnius, Panstrongylus y Triatoma (Messenger et al., 2015). Se han reportado casos de transmisión congénita con todas las DTU, excepto en TcIV, en Argentina, Bolivia, Chile, Colombia y Paraguay (Zingales et al., 2012).
T. cruzi TcV se ubica principalmente en el Cono Sur, el Gran Chaco y, según reportes esporádicos, también en Colombia, Ecuador y Perú; se ha registrado en el extremo sur de Brasil (Cura & Schijman, 2013; Messenger et al., 2015; Zingales, 2018). Esta DTU es transmitida por T. infestans (Messenger et al., 2015), y suele asociarse con cardiomiopatía y megasíndromes digestivos.
T. cruzi TcVI, extendida por el norte de Ecuador y Colombia, el Cono Sur y el Gran Chaco, se transmite por el vector T. infestans. Los pacientes infectados con esta DTU presentan cardiomiopatía y megasíndromes digestivos (Messenger et al., 2015).
En cuanto a T. cruzi Tcbat, esta DTU no se desarrolla en triatominos, pero los cimícidos son vectores potenciales. Además, Tcbat se ha aislado de especies de Chiroptera (murciélagos) en Panamá y Colombia, así como en el centro y sureste de Brasil (Messenger et al., 2015; Zingales, 2018).
Estudios de tipificación molecular de T. cruzi en ejemplares de M. pallidipennis recolectados en el municipio de Tepecoacuilco, en el estado de Guerrero, México, confirmaron que la cepa T. cruzi TcI está presente en esta región del país (Aparicio-Burgos, Romero-Cortés, López-Ramírez, Reyes-Rios & Campos-Hernández, 2021). Sin embargo, en otro estudio de caracterización molecular en el vector Triatoma dimidiata del estado de Veracruz, se encontró que TCI solo estaba presente en el 27 % de las cepas identificadas, y se reportó por primera vez la presencia de las DTU´s TcII, TcIII, TcIV y TcV, lo que sugiere que en México existe una mayor diversidad de T. cruzi (Ramos-Ligonio, Torres-Montero, López Monteon & Dumonteil, 2012).
Transmisores de T. cruzi
La subfamilia Triatominae (orden Hemiptera, familia Reduviidae), a la que pertenecen los insectos triatominos, está compuesta por 149 especies, distribuidas principalmente en el continente americano. Tras eclosionar del huevo, los triatominos pasan por cinco estadios ninfales hasta llegar al imago o adulto (Figura 3) (Dujardin, Schofield & Panzera, 2002; Jurberg & Galvão, 2006). Los triatominos son hematófagos; la mayoría se alimentan de sangre de mamíferos o aves, aunque existen reportes sobre especies que pueden consumir sangre de reptiles o anfibios (Schofield, 1979; Jurberg & Galvão, 2006). Algunas especies de triatominos pueden alimentarse de savia de las plantas, azúcar de forma experimental, sangre consumida por otros insectos (cleptohematofagia), heces de otros triatominos (coprofagia) o hemolinfa de otros triatominos (hemolinfagia) (Jurberg & Galvão, 2006; Díaz-Albiter et al., 2016; De Fuentes-Vicente & Gutiérrez-Cabrera, 2020). Machos y hembras se alimentan de sangre durante los cinco estadios de ninfa y como adultos, aunque la cantidad de sangre que ingieren varía según la especie y la etapa de vida en la que se encuentran (Jurberg & Galvão, 2006; De Fuentes-Vicente & Gutiérrez-Cabrera, 2020).

Elaboración personal.
Figura 3 Ciclo de vida de los triatominos. Vectores de Trypanosoma cruzi; su desarrollo comprende el huevo (son elípticos y poseen un opérculo, por donde emerge la ninfa), cinco estadios ninfales (n1-n5; crecimiento incompleto de las alas y la genitalia; los primordios alares son visibles en las n5) y el adulto, hembra o macho (alas y genitales desarrollados y diferenciados; las hembras poseen un aparato ovipositor).
El tracto digestivo de los triatominos se divide en tres regiones principales: intestino medio anterior (estómago), intestino medio posterior y recto (Kollien & Schaub, 2000). Los tubos de Malpighi o nefridios, que constituyen el principal sistema excretor y osmorregulador en los triatominos se encuentran flotando en la hemolinfa, son tubos ciegos que desembocan en el intestino medio posterior, incorporan los líquidos de desecho del metabolismo y forman la orina (Dujardin et al., 2002).
Estos insectos son, por lo general, de hábitos nocturnos, y durante el día permanecen en acinesia (sin movimiento) en sus refugios (grietas, entre hojas, debajo de la corteza de los árboles o basura), aunque en condiciones adversas pueden salir a alimentarse durante el día (Schofield, 1979; Jurberg & Galvão, 2006; De Fuentes-Vicente & Gutiérrez-Cabrera, 2020). Cuando pican a los hospederos humanos durante la noche, lo hacen en partes del cuerpo que están frecuentemente expuestas (por eso se cree que muestran preferencia por picar en la cara). Las picaduras son indoloras, porque la saliva de los triatominos tiene acción anestésica y anticoagulante (Schofield, 1979; Jurberg & Galvão, 2006). Algunos autores sugieren que la actividad nocturna de varias especies de triatominos se debe a la exposición a altas temperaturas y a la radiación solar que afectan su desarrollo hormonal y la síntesis de proteínas (Schofield, 1979). En ausencia de la luz, estos insectos perciben las señales químicas de sus huéspedes, como el dióxido de carbono, el ácido isobutírico, el 1-octen-3-ol (octenol) y el ácido L-láctico (De Fuentes-Vicente & Gutiérrez-Cabrera, 2020); no obstante, la atracción por dióxido de carbono no es tan importante en los triatominos (Jurberg & Galvão, 2006; De Fuentes-Vicente & Gutiérrez-Cabrera, 2020). En cambio, sí lo es la radiación térmica del hospedero que les permite a los triatominos localizar los vasos sanguíneos de éste y alimentarse de manera más eficiente (De Fuentes-Vicente & Gutiérrez-Cabrera, 2020). Los triatominos suelen colonizar hábitats específicos, con fácil acceso a los huéspedes vertebrados, (Schofield, 1979; Dujardin et al., 2002) lugares que los protegen de la luz y las altas temperaturas (Schofield, 1979). La tolerancia de los triatominos a una gran diversidad de ambientes favorece su amplia distribución en el continente americano (De Fuentes-Vicente & Gutiérrez-Cabrera, 2020).
Los géneros más importantes desde el punto de vista epidemiológico para la transmisión de T. cruzi son Triatoma, Rhodnius y Panstrongylus (Dujardin et al., 2002). En América Latina por el número de países donde se distribuyen se encuentran principalmente Triatoma infestans (presente en siete países al sur de la cuenca amazónica), Rhodnius prolixus (en América Central y países al norte de la cuenca del Amazonas) y T. dimidiata (desde México hasta el norte del Perú) (Dujardin et al., 2002). Otras especies, vectores, importantes son T. brasiliensis y Panstrongylus megistus (Jurberg & Galvão, 2006).
En un estudio realizado en México se reportó que 19 de las 32 especies mexicanas de triatominos colonizan viviendas y están infectadas con T. cruzi (Ramsey et al., 2015). Tres de las especies principales de triatominos (T. longipennis, T. mexicana y T. barberi), transmisoras de T. cruzi se localizan en asentamientos humanos, y afectan tanto a las comunidades rurales como a las urbanas. También se conoce que especies como T. rubida y T. protracta muestran preferencia por las áreas urbanas. Lo anterior demuestra que el hábitat de los triatominos se ha urbanizado en varias regiones, y pone de manifiesto su alta tolerancia a los ambientes perturbados por la actividad humana (Ramsey et al., 2015).
Efecto de T. cruzi en el vector
La viabilidad, el desarrollo y la multiplicación del parásito dependen de su capacidad para invadir al insecto vector y perdurar en él. Esto depende de un equilibrio mediado por interacciones fisiológicas y bioquímicas con el triatomino (Garcia, Genta, Azambuja & Schaub, 2010; Goubiére, Dorn, Tripet & Dumonteil, 2012). De hecho, se han investigado los efectos de T. cruzi en los triatominos, a través de la biología del insecto, su comportamiento, la colonización del intestino por el parásito, el sistema inmunológico del triatomino y la microbiota asociada (Figura 4).

Elaboración personal.
Figura 4 Interacción de Trypanosoma cruzi con el vector. Las principales defensas que el triatomino aplica para contrarrestar los efectos de T. cruzi. NO = óxido nítrico.
La presencia de T. cruzi puede limitar el desarrollo de las ninfas. Se ha demostrado una reducción en el tamaño de los insectos infectados y una menor tasa de supervivencia. Cuando T. pallidipennis se infectó experimentalmente con dos aislados distintos del parásito, uno de Morelos y otro de Chilpancingo, la mortalidad fue alta en comparación con el grupo testigo (libre de infección); asimismo, se observó una reducción en el tamaño de las ninfas del quinto estadio hacia adultos. Este efecto podría deberse al gasto de la reserva energética necesaria para la muda hacia el estadio adulto y para reproducirse (Cordero-Montoya et al., 2019). En condiciones de inanición, se establece competencia entre T. cruzi y el vector por metabolitos esenciales, aunque algunos autores clasifican a T. cruzi como subpatógeno para el vector, porque no ocasiona una enfermedad en él, a diferencia de un patógeno verdadero (Vallejo, Guhl & Schaub, 2009; Schaub et al., 2011). En un estudio para evaluar si el parásito modificaba el comportamiento de los insectos adultos, se utilizaron “chinches” de las especies T. pallidipennis y T. longipennis. y dos aislados de T. cruzi de (Chilpancingo y Morelos, México); se encontró que los parásitos eran más activos y tenían más probabilidades de detectar el olor humano cuando estaban infectados, lo que sugiere que T. cruzi podría manipular el comportamiento de los insectos vectores (Ramírez-González et al., 2019).
Cada región anatómica en el intestino del vector (estómago o intestino medio anterior, intestino medio posterior y recto) tiene diferentes funciones y segrega enzimas, carbohidratos y proteínas específicas. En la saliva de T. infestans se encontró sialidasa con la capacidad de lisar a los tripomastigotes y epimastigotes de los cultivos celulares de T. cruzi. Se sabe que esta proteína determina la susceptibilidad de las poblaciones de triatominos a la infección con una cepa específica de T. cruzi (Garcia et al., 2010).
El estómago o intestino medio anterior almacena y concentra la sangre ingerida. En esta región se producen aglutininas y hemolisinas, para la hemólisis de los eritrocitos.
En el intestino medio posterior se lleva a cabo la digestión de las proteínas y la absorción de los nutrientes. La catepsina B (principal enzima digestiva) no se ve afectada por el parásito; en contraste, la actividad de la catepsina D se incrementa con la presencia de T. cruzi, y ésta se intensifica de 1 a 3 días después de que el triatomino ingiere sangre infectada (Garcia et al., 2010; Schaub et al., 2011). Para eludir la acción de las catepsinas (proteasas) en esta región del intestino, T. cruzi posee en su superficie un inhibidor de cisteína proteasa llamado chagasina; también se ha sugerido que los epimastigotes producen mucinas específicas para protegerse de las proteasas (Garcia et al., 2010; Kollien & Schaub, 2000).
Cuando el parásito coloniza el intestino medio posterior, no tiene efectos adversos sobre las membranas perimicroviliares ni sobre las células de la pared intestinal; sin embargo, en el recto del vector, T. cruzi inserta su flagelo entre las capas de cera y en las almohadillas rectales, y se ha sugerido que estas alteraciones afectarían los procesos de absorción de los triatominos. Una fuerte colonización del parásito en el recto altera la composición del contenido rectal: se reduce la concentración de aminoácidos libres y cambian los niveles de ciertas enzimas; por ejemplo, las carboxipeptidasas, aminopeptidasas y catepsinas en el recto son hidrolizadas por las proteasas de superficie presentes en T. cruzi (Kollien & Schaub, 2000; Schaub et al., 2011).
En los periodos prolongados sin alimento (inanición) en los triatominos se reduce la densidad poblacional de los parásitos en el intestino, y únicamente se conserva el 1% de la población inicial. La inanición afecta también la composición de la población de T. cruzi; las formas intermedias gruesas y delgadas de flagelo largo o corto, formas en división y esferomastigotes, redondeados y con flagelo corto, que normalmente constituyen el 2% de la población, aumentan hasta el 20% durante un periodo de 2-3 meses de inanición (Kollien & Schaub, 2000; Schaub et al., 2011).
Posterior a la ingestión de la sangre, el número de epimastigotes en el intestino aumenta en proporción directa con la cantidad de sangre que ha ingerido el vector. En el recto ocurre lo contrario, con la excreción, un tercio de la población total de parásitos se elimina con las heces y la orina del insecto, que contiene tripomastigotes metacíclicos; como consecuencia, éstos son incapaces de adherirse al tracto intestinal del vector (Vallejo et al., 2009). Se han localizado en los tubos de Malpighi un fragmento de la αD-globina y el ácido oleico, que inducen a la metaciclogénesis en los epimastigotes de T. cruzi que permanecen en el recto un par de días después de que el triatomino se alimenta de sangre (Schaub et al., 2011).
La ingestión de tripomastigotes estimula la respuesta inmunológica en el intestino del triatomino R. prolixus, pues la expresión de los genes de lisozimas, defensinas y óxido nítrico sintasa aumenta tras la ingestión de la sangre infectada; esto puede ser una reacción de defensa general contra los microorganismos. La respuesta inmune de los insectos comprende respuestas celulares (hemocitos) y humorales, como la generación de profenoloxidasa (PPO), cascadas de coagulación de la hemolinfa, especies reactivas de oxígeno (ROS), especies reactivas de nitrógeno (RNS) y péptidos antimicrobianos (AMPs) (Garcia et al., 2010; Schaub et al., 2011; Díaz-Garrido, Sepúlveda-Robles, Martínez-Martínez & Espinoza, 2018). Se han descrito tres procesos de defensa en los triatominos contra los parásitos: fagocitosis, formación de nódulos y encapsulación. La respuesta inmune involucra las vías de señalización IMD, Toll y Jak-STAT (Flores-Villegas et al., 2015).
Se ha reportado un fenómeno de inmunosupresión en el intestino de T. infestans, porque los insectos infectados con T. cruzi fueron atacados por hongos y bacterias que no se encuentran en insectos libres del parásito (Jiménez-Cortés et al., 2020).
En un estudio sobre los efectos de la infección, por T. cruzi, en la microbiota intestinal de los triatominos, se aisló la microbiota bacteriana del intestino anterior y posterior de M. pallidipennis, identificando 17 especies de bacterias, principalmente de los géneros Bacillus y Staphylococcus. No se encontraron diferencias en el número de especies bacterianas con respecto al estado de infección de los triatominos (infectados o no-infectados); sin embargo, el índice de diversidad de Shannon-Weaver (que refleja lo heterogénea que es una comunidad) fue más alto en los controles no infectados que en los insectos infectados (Jiménez-Cortés et al., 2020). En el estómago de R. prolixus se aislaron cepas de la bacteria Serratia marcescens y se encontró que la bacteria produce el pigmento prodigiosina y puede desarrollar filamentos que le permiten unirse a los epimastigotes para finalmente eliminarlos (Garcia et al., 2010). También se ha establecido que el desarrollo de T. cruzi en R. prolixus es mejor en especímenes que alojan simbiontes, pero cuando la infección se ha establecido, el desarrollo de los parásitos es mejor en insectos aposimbióticos (con ausencia de simbiontes) (Vallejo et al., 2009; Schaub et al., 2011).
Efecto de T. cruzi en el hospedero
En la enfermedad de Chagas se distingue una fase aguda y otra crónica. La fase aguda suele ser asintomática, pero si se presentan los síntomas, estos son fiebre prolongada y malestar general, si la transmisión fue vectorial, en el sitio donde la chinche picó al hospedero se presenta un chagoma, llamado signo de Romaña si se localiza en las mucosas oculares (Rassi et al., 2010).
Durante la fase aguda, la respuesta inmune innata es crucial para controlar la infección parasitaria. Los receptores tipo Toll (TLRs) son los principales mediadores de la respuesta; estas proteínas transmembranales forman parte de un grupo de moléculas denominadas receptores de reconocimiento de los patrones moleculares (PRRs), asociados con los patógenos (PAMPs). Entre los PAMPs detectados en T. cruzi se encuentran las glicoproteínas parecidas a las mucinas (GPI-mucinas), ubicadas en la membrana celular de los tripanosomátidos; las GPIs presentes en los tripomastigotes son reconocidas por el TLR2, que actúa como inmunorregulador. El parásito secreta también glicoinositolfosfolípidos (GIPLs), reconocidos por el TLR4; los ratones que no expresan TLRs desarrollan altos niveles de parasitemia y mortalidad, además de una baja producción de citocinas. TLR9, otro receptor tipo Toll capaz de reconocer el DNA del parásito, es crucial para establecer una respuesta tipo Th1 (Cristovao-Silva, Brelaz-de-Castro, Hernandes & Pereira, 2021).
Los macrófagos, las células dendríticas y las células natural killer (NK) activan la respuesta inflamatoria, y como respuesta a la presencia del parásito aumenta la producción de citocinas como la interleucina 12 (IL-12), el factor de necrosis tumoral alfa (TNF-α) y el interferón gamma (IFN-γ), además de las quimiocinas (proteínas auxiliares en la migración de los leucocitos) CCL2, CCL3, CCL4 y CXCL10 (Boscardin et al., 2010).
Conforme la infección progresa, se producen anticuerpos, linfocitos T CD8+ (citotóxicos) y linfocitos T CD4+ (respuesta tipo Th1), además de altos niveles de IFN-γ. Algunos estudios con pacientes en la fase aguda señalan en esta etapa un aumento de las citocinas proinflamatorias involucradas en la resistencia a la infección por T. cruzi, como IFN-γ, TNF-α e IL-6. En contraste, la respuesta tipo Th2, con niveles aumentados de IL-4, se le relaciona con la susceptibilidad a la enfermedad (Cristovao-Silva et al., 2021).
La activación del factor nuclear potenciador de cadenas ligeras kappa de las células B activadas (NF-κB) y la producción de citocinas proinflamatorias vincula la respuesta innata con la adaptativa; por otra parte, la producción de IL-12 en macrófagos, inducida por T. cruzi, interfiere en la producción de IFN-γ por activación de células NK y la inducción de una respuesta Th1. La IL-12 activa la producción de células NK y células T CD4+ y CD8+; junto con el IFN-γ y TNF-α, ambos tipos celulares estimulan la producción de óxido nítrico (NO), que contribuye al control de la división intracelular del parásito y a su eliminación (Boscardin et al., 2010).
El parásito produce moléculas que le permiten evadir al sistema inmune; por ejemplo, los tripomastigotes metacíclicos invaden las células del hospedero por acción de proteínas similares a la transialidasa (gp82), un complejo proteico similar a la mucina (gp35/gp50) y las proteínas de superficie asociadas a la mucina (MASPs). Por otra parte, la enzima cruzipaína bloquea la activación del NF-κB, lo que conduce a una disminución en la producción de IL-12 por los macrófagos (De Castro Neto, Da Silveira & Mortara, 2021). Una vez que el parásito logra ingresar a la célula, las peroxidasas TcGPXI, TcGPXII, TcAPX, TcCPX y TcMPX le permiten resistir el estrés oxidante. La transialidasa, es un factor de virulencia, que limita la respuesta proinflamatoria durante la presentación de antígenos y estimula la respuesta antiinflamatoria mediante la producción de IL-10, favorece la infección y la presencia del parásito en los tejidos (Freire-de-Lima, Fonseca, Oeltmann, Mendonça-Previato & Previato, 2015). Se ha demostrado que las mucinas protegen a T. cruzi de la acción de los anticuerpos y evitan la activación de los linfocitos T (Boscardin et al., 2010; Cristovao-Silva et al., 2021).
La fase aguda dura de 4 a 16 semanas, y la parasitemia disminuye después de 90 días. Los síntomas de esta fase se resuelven de forma espontánea, y los pacientes pasarán a la fase crónica si no se les brinda tratamiento (Pérez-Molina & Molina, 2018). La fase crónica presenta dos formas: la indeterminada o asintomática y la determinada o sintomática (Carabarin-Lima et al., 2013). En la forma indeterminada no se presentan signos ni síntomas de la enfermedad (Rassi et al., 2010) y en la forma determinada los pacientes presentan afectaciones cardiacas o gastrointestinales (Alonso-Padilla et al., 2019). La miocardiopatía chagásica crónica (CCC) es la manifestación clínica más frecuente y grave (Carabarin-Lima et al., 2013).
En la fase crónica se presenta una respuesta de tipo Th1, con alta producción de IFN-γ, TNF-α, IL-2, IL-6, Il-9 e IL-12. En contraste, existe un bajo nivel de citocinas de la respuesta Th2: IL-4, IL-5, IL-10 e IL-13 en pacientes con sintomatología cardiaca o digestiva. Al respecto, se ha propuesto emplear las concentraciones de algunas citocinas, entre ellas TGF-β, IL-1β y TNF-α, como biomarcadores de fibrosis en el miocardio. La expresión de IL-6 también es mayor en pacientes con la forma cardiaca de la enfermedad a diferencia de los pacientes con la forma indeterminada que producen IL-10. La respuesta inmune tipo 1, además de ser importante en la fase aguda, resulta crucial en el desarrollo de la fase cardiaca de la enfermedad (Salazar-Schettino et al., 2016). Se considera que IL-1β es un mediador de la hipertrofia del miocardio; su expresión contribuye al desarrollo y la progresión de fallas en el corazón (Boscardin et al., 2010).
En la cardiopatía crónica se presenta un proceso inflamatorio crónico, mediado principalmente por TGF-β, con presencia de focos inflamatorios que generan hipertrofia en los miocitos e intensa fibrosis y progresivo deterioro de la función cardiaca (Salazar-Schettino et al., 2016).
En los casos de cardiopatía chagásica se observa miocarditis, que conduce a un deterioro de la función contráctil y dilatación en las cuatro cámaras del corazón. Asimismo, se ha reportado aneurisma apical ventricular izquierdo, anormalidades en el movimiento de la pared, destrucción de las células del miocardio, fibrosis, edema e infiltrados mononucleares (Rassi et al., 2010).
En los casos crónicos digestivos (megaesófago y megacolon) se ha reportado destrucción de los ganglios autonómicos; las manifestaciones pueden variar desde desórdenes en la motilidad hasta acalasias. Los pacientes con megaesófago muestran un mayor riesgo de cáncer en este órgano; en el megacolon se presenta constipación, que conduce a un fecaloma, vólvulo e isquemia; el sigmoide y el recto se encuentran dilatados en casi todos los casos de megacolon (Pérez-Molina & Molina, 2018).
Diagnóstico y tratamiento de la enfermedad de chagas
Durante la fase aguda, la parasitemia es alta, y por eso el diagnóstico se establece mediante la detección microscópica de los tripomastigotes en la sangre (Rassi et al., 2010; Zingales, 2018) (Tabla III); esto se realiza con métodos parasitológicos directos como el de la gota fresca (se examina en el microscopio una gota de sangre del paciente), gota gruesa (se aplican movimientos circulares sobre la gota utilizando la esquina de otro portaobjetos para desfibrinarla) o frotis (se extiende la gota a lo largo del portaobjetos, y se tiñe con el método de Giemsa). También se utilizan técnicas de concentración sanguínea, como el microhematocrito o las pruebas de Strout (Mandal, 2014; Salazar-Schettino et al., 2016). Asimismo, pueden emplearse métodos parasitológicos indirectos, como el hemocultivo y el xenodiagnóstico (uso de vectores mantenidos en el laboratorio bajo condiciones controladas de temperatura y humedad [28 °C y 60% HR], libres de infección parasitaria, que se depositan en un frasco cubierto con una gasa y se les permite alimentarse del paciente con sospecha de la enfermedad durante 20 minutos) (Zingales, 2018).
Tabla III Diagnóstico y tratamiento de la enfermedad de Chagas. Imágenes: Cortesía Dra. Margarita Cabrera-Bravo y Dra. A. Laura Flores-Villegas.
En la fase crónica, la parasitemia es baja e intermitente y las pruebas usadas para la fase aguda no son de utilidad (Tabla III). En cambio, el diagnóstico se confirma con la respuesta inmune del huésped ante el parásito mediante la detección de los anticuerpos IgG anti-T. cruzi en pruebas serológicas como la inmunofluorescencia indirecta (IFI), la hemaglutinación indirecta (HAI) y el ensayo por inmunoadsorción ligado a las enzimas (ELISA). De acuerdo con la OMS, se requieren dos ensayos serológicos diferentes positivos para confirmar un diagnóstico de infección por T. cruzi (Rassi et al., 2010; Salazar-Schettino et al., 2016).
La PCR (reacción en cadena de la polimerasa) es una prueba molecular que se basa en la amplificación de las secuencias del DNA de T. cruzi (Mandal, 2014). Su sensibilidad para el diagnóstico de la enfermedad es menor, debido a las variaciones en la carga parasitaria (Salazar-Schettino et al., 2016); sin embargo, esta prueba puede ser útil para confirmar el diagnóstico cuando la serología no sea concluyente, y para monitorear el tratamiento (Rassi et al., 2010). Por otra parte, la PCR tiene bajo costo, por lo que se emplea con frecuencia en la investigación y el seguimiento de la enfermedad (Bern, 2015).
El diagnóstico de la enfermedad de Chagas en recién nacidos es crucial, porque tienen un 100% de probabilidad de curación. Para el diagnóstico deben cumplirse los siguientes criterios: (1) ser hijo de madre seropositiva a T. cruzi; (2) PCR positiva o detección del parásito en la sangre durante el nacimiento o en los primeros meses de seguimiento, y (3) detección de anticuerpos anti-T. cruzi (IgG) a partir de los nueve meses de edad; en este tiempo, los anticuerpos maternos ya habrán desaparecido (Álvarez-Hernández et al., 2018).
Además de las pruebas específicas para cada fase de la enfermedad, en todos los casos debe realizarse un electrocardiograma (ECG), una telerradiografía de tórax en proyección posteroanterior (PA) y un ecocardiograma transtorácico (ECO) en el marco de la evaluación clínica (Salazar-Schettino et al., 2016; Lidani et al., 2019).
Actualmente, la totalidad de la sangre y sus componentes empleados para transfusión en México deben tamizarse, conforme a lo establecido en la Norma Oficial Mexicana (NOM-253-SSA-1-2012) “Para la disposición de la sangre humana y sus componentes con fines terapéuticos”. Esto mejora la seguridad en las unidades de captación sanguínea, por lo que la incidencia de la sangre con T. cruzi (0.32%) ha disminuido en el país durante los últimos cinco años (Salazar-Schettino, Bucio-Torres, Cabrera-Bravo & Rojo-Medina, 2020).
Para el tratamiento de la enfermedad de Chagas, el benznidazol (que actúa dañando el DNA mitocondrial del parásito) y el Nifurtimox (que induce al estrés oxidante, inhibiendo el crecimiento de los parásitos) son los únicos fármacos con eficacia probada (Rassi et al., 2010). Sin embargo, su eficacia se reduce durante la etapa crónica de la enfermedad (Alonso-Padilla et al., 2019). Idealmente, el tratamiento debe administrarse por 60 días, pero en algunos casos se producen reacciones adversas, que provocan intolerancia en algunos pacientes, y el tratamiento debe acortarse a 30 días (Salazar-Schettino et al., 2016; Alonso-Padilla et al., 2019). Estos medicamentos no están disponibles en el comercio como ya se mencionó; su distribución es controlada por la Secretaría de Salud (Salazar-Schettino et al., 2016); en los Estados Unidos, su venta no está autorizada por la Administración de Alimentos y Medicamentos, pero pueden obtenerse en los CDC (Centros para el Control y Prevención de Enfermedades) (Bern, 2015).
Conclusiones
El número de casos de la enfermedad de Chagas se ha incrementado en diferentes regiones del mundo, y ya no es una enfermedad exclusiva de regiones tropicales o de Latinoamérica. La incidencia ha aumentado porque el parásito tiene la capacidad de transmitirse de forma diferente, aunque la vía principal es el vector triatomino, conocido comúnmente como “chinche besucona”.
La relación triatomino -T. cruzi ha ganado interés en época reciente, en un intento para comprender cómo interactúa el parásito con el insecto y conocer más sobre su ciclo de vida, puesto que la morfología y la diferenciación del parásito están estrechamente relacionadas con los componentes de cada segmento del intestino del triatomino. Asimismo, el estudio de estos componentes podría servir para diseñar estrategias de control vectorial. En contraste, la respuesta inmune del hospedero ante T. cruzi se ha estudiado con más detalle, y hay consenso en el papel de la respuesta inmune innata y de varias citocinas como mecanismos de defensa primordiales para eliminar al parásito en la fase aguda, o bien para permitir su evolución hacia la fase crónica. Se ha propuesto emplear algunas de estas citocinas como biomarcadores en la etapa de daño cardiaco.
La diversidad genética de T. cruzi queda de manifiesto con la existencia de cepas o aislados con diferencias notorias en cuanto a su virulencia. Al respecto, es indispensable conocer la caracterización biológica de los aislados para definir su grado de virulencia. Esta virulencia, como se mostró anteriormente, puede estar asociada con la especie del vector existente en cada región. Por ello, conocer la distribución y la biología de los vectores en distintas regiones del mundo es de importancia crucial para diseñar programas de control del insecto. Sólo en México se han identificado 32 especies de triatominos involucrados en la transmisión de T. cruzi.
Los métodos de diagnóstico deben seleccionarse en función de la fase de la enfermedad en la que se encuentra el paciente; es crucial una elección correcta para la certeza de los resultados. Debido a la presencia de parásitos circulantes en la fase aguda, los métodos de diagnóstico parasitológicos presentan una mayor sensibilidad. En la fase crónica de la enfermedad, sea asintomática o sintomática, hay una mayor cantidad de anticuerpos anti-T. cruzi circulando, por lo que deben emplearse métodos de diagnóstico serológicos o moleculares; el diagnóstico confirmatorio requiere de dos pruebas serológicas positivas.
Se le ofrece tratamiento a la población infectada con T. cruzi en etapas avanzadas de la enfermedad, cuando existen lesiones irreversibles, por lo que la detección de casos y la identificación de la transmisión activa permitirá brindar un tratamiento oportuno.
Por lo anterior, es vital conocer aspectos todavía desconocidos de la biología de T. cruzi y su impacto en la dinámica de la transmisión del parásito, para diseñar estrategias de prevención en la población expuesta.










nueva página del texto (beta)